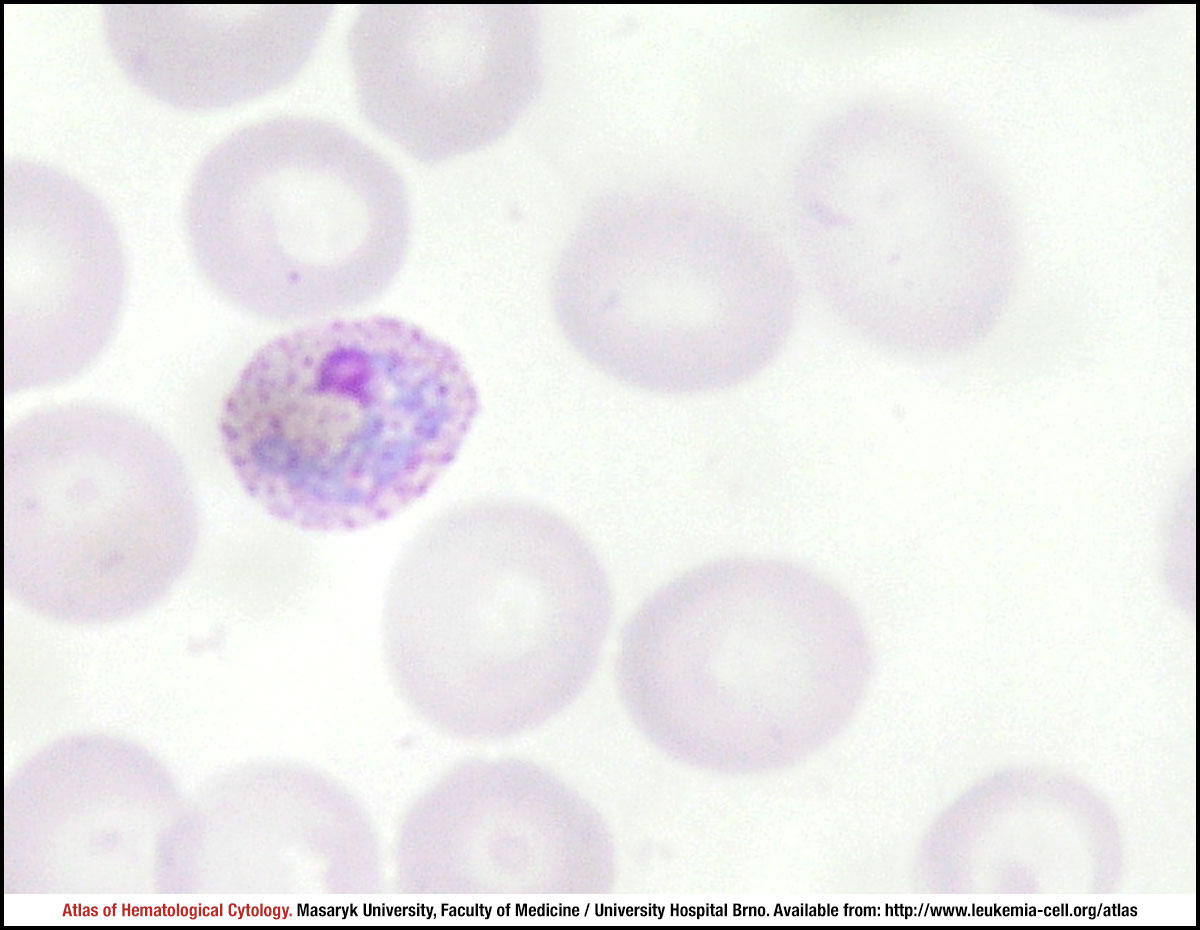

Cell constants
2 9 фунта
Ла рош молочко
Когда пасха в 2025 и родительский день
Кораблик до петергофа 6 букв
Торик рассказы
Какой иностранный язык лучше учить
5meemet
Индексация пенсии с апреля 2025 года
Сайт который я сейчас
Вайнер магнитогорск
Гайд на синцю
Как вставить скопированный текст на андроиде
Петухово работа вакансии
Cell constants 114 фото